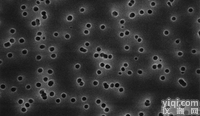
Millipore聚碳酸酯白色光面生物分析<em>表面</em><em>滤膜</em>

表面滤膜AABG02500 日本密理博表面滤膜AABG02500
- 型号:表面滤膜AABG02500
- 供应商:易购安(北京)科技有限公司
- 供应商报价:面议
- 标签:日本密理博表面滤膜AABG02500,-1,易购安(北京)科技有限公司
| 品牌 | MilliQ/默克密理博 |
|---|
Aook 2016-06-20
易购安(北京)科技有限公司
原装进口工业产品 http://www.egoan。。cn
:杨女士,
:
日本密理博表面滤膜AABG02500 入数(枚) | |
商品CD | 15-7192 |
商品名 | ミリポア AABG02500 |
フィルター 100入 |
セルロース混合エステルメンブレン MF-MILLIPORE MEMBRANE
· 生物学的に不活性なセルロースアセテート及びニトロセルロースの混合物からできたメンブレン。
| 商品CD | 15-7192 | ||||||
| カタログ商品名 | セルロース混合エステルメンブレン | ||||||
| 型式 | AABG02500 | ||||||
| 各種マーク | |||||||
| 孔径(μm) | 0.8 | ||||||
| 直径(mm) | 25φ | ||||||
| 色 | 黒 格子入 | ||||||
| 入数(枚) | 100 | ||||||
· 直径と孔径の種類が豊富で分析?研究用として幅広くお使い頂けます。
· うすい酸、アルカリ、脂肪族や芳香族水溶液に安定です(強酸?強塩基や無極性溶液には耐性がありません)。